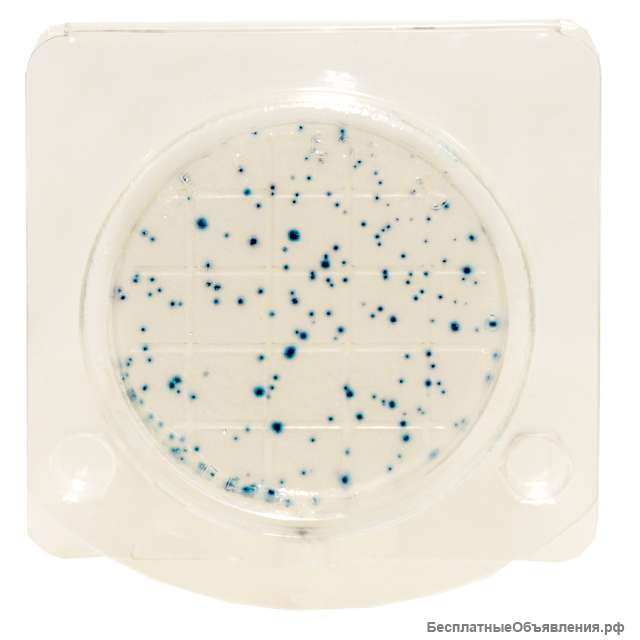
Экспресс-тест на определение БГКП колиформные бактерии в т. ч. Escherichia coli (петритест)
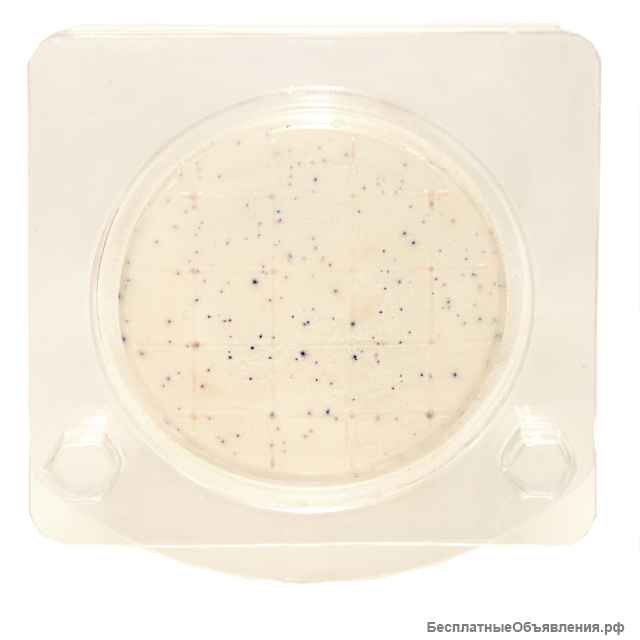
Экспресс-тест на определение БГКП колиформные бактерии в т. ч. Escherichia coli (петритест)

Экспресс-тест на определение БГКП колиформные бактерии в т. ч. Escherichia coli (петритест)
Готовый экспресс-тест (сухая хромогенная среда) для микробиологического анализа сырья, полуфабрикатов, готовых продуктов питания, окружающей среды и пр. Тщательный биоконтроль на предприятиях пищевой отрасли и в быту для определения микробиологической безопасности пищи, воды, жилого или рабочего пространства.
- Соответствуют требованиям действующего санитарного законодательства РФ
- Срок годности два года!
- Не требует специальный условий хранения.
- Возможность визуализировать колонии по цвету.
- Удобство подсчета колоний.
- Соответствует классическим методам исследований.
- Результаты через 24 часа.
- Соответствуют требованиям действующего санитарного законодательства РФ
- Срок годности два года!
- Не требует специальный условий хранения.
- Возможность визуализировать колонии по цвету.
- Удобство подсчета колоний.
- Соответствует классическим методам исследований.
- Результаты через 24 часа.
| Цена: |
80 руб
|
| Город: |
Саратов
|
| Тип: | Продаю |
| Автор: |
|
Регистрация с 05.04.2023 
|
|
| Сайт: | petritest.ru/ |
| Дата: | 10.04.2023 11:15 |
| Номер: | 2581688 |
Сделать объявление:
Ссылка на это объявление:
Похожие объявления

Газорегуляторные пункты блочные ПГБ-02-2У1, ПГБ-04-2У1, ПГБ-05-2У1, ПГБ-07-2У1
490 000 руб
24.11.2025

Подшипник 29236-E1-MB производитель FAG
50 000 руб
Вчера

Шарнирный наконечник SI10T/K внутренняя резьба
220 руб
Вчера

Газорегуляторные пункты ГРПШ-02-2У1, ГРПШ-03М-2У1, ГРПШ-03БМ-2У1, ГРПН-300-2У1
146 000 руб
24.11.2025

Куплю радиодетали приборы ссср
Без цены
27.02.2024

Газорегуляторные пункты ГРПШ-13-2НУ1, ГРПШ-13-2ВУ1, УГРШ-50Н, УГРШ-50В, ГСГО-50
212 000 руб
24.11.2025

Подшипник 7226-B-MP-UA производства FAG
15 000 руб
Вчера

Гаминатор новоматик FV801 продаю
150 000 руб
Вчера

Навигационное оборудование. Саратов
1 650 000 руб
28.07.2023

Подшипник 7318-B-MP-UA производства FAG
7 000 руб
Вчера

Ручной станок для намотки статаорных обмоток двигателя
500 руб
28.03.2026

Газорегуляторные пункты блочные ПГБ-13-2НУ1, ПГБ-13-2ВУ1, ПГБ-50
610 000 руб
24.11.2025

Купим дорого радиодетали СССР: Конденсаторы, микросхемы, транзисторы, реле, переключатели, платы
Без цены
17.11.2025

Газорегуляторные пункты ГРПШ-04-2У1, ГРПШ-05-2У1, ГРПШ-07-2У1, ГРПН-300-01
136 000 руб
24.11.2025

Земснаряд Ахтарец 1400 / 40 дизельный, гидро. ЗМК
33 300 000 руб
02.11.2025

Выездная очистка масел
Без цены
17.04.2026

Подшипник F-16201 FERSA
1 200 руб
Вчера

Таблички из алюминия
Без цены
12.05.2025

Ролик крыши 55.3367
320 руб
Вчера

Фильтрация масел
100 руб
17.04.2026

Экспресс-тест на определение Стрептококка (петритест)
1 900 руб
15.04.2023

Фильтроэлементы очистки тонкой и грубой масла и топлива
100 руб
21.05.2025

Купим радиоприборы СССР: Осциллографы, частотомеры, вольтметры, самописцы, генераторы сигн, платы
Без цены
17.11.2025

Подшипники
1 000 руб
05.03.2024

Корпус подшипника в сборе UCP203
350 руб
Вчера

Круглый корпус подшипника в сборе UCFC204 вал 20 мм
420 руб
Вчера

Пункты учета газа ПУРГ, ШУУРГ, БУУРГ, УУРГ, УУГ
160 000 руб
24.11.2025

Промышленные дымоходы. Дымовые трубы.
35 000 руб
26.04.2026

Газорегуляторные пункты ГРПШ, ШГРП, ШРП, ПРДГ, ГРПБ, ПГБ, ГСГО, ГРПН, ГРП, УГРШ
136 000 руб
24.11.2025

Шар 20,638 гост 3722-81 шх15
18 руб
Вчера

Пункты газорегуляторные блочные ПГБ-02-2У1, ПГБ-04-2У1, ПГБ-05-2У1, ПГБ-07-2У1 предназначены для редуцирования высокого или среднего давлени...